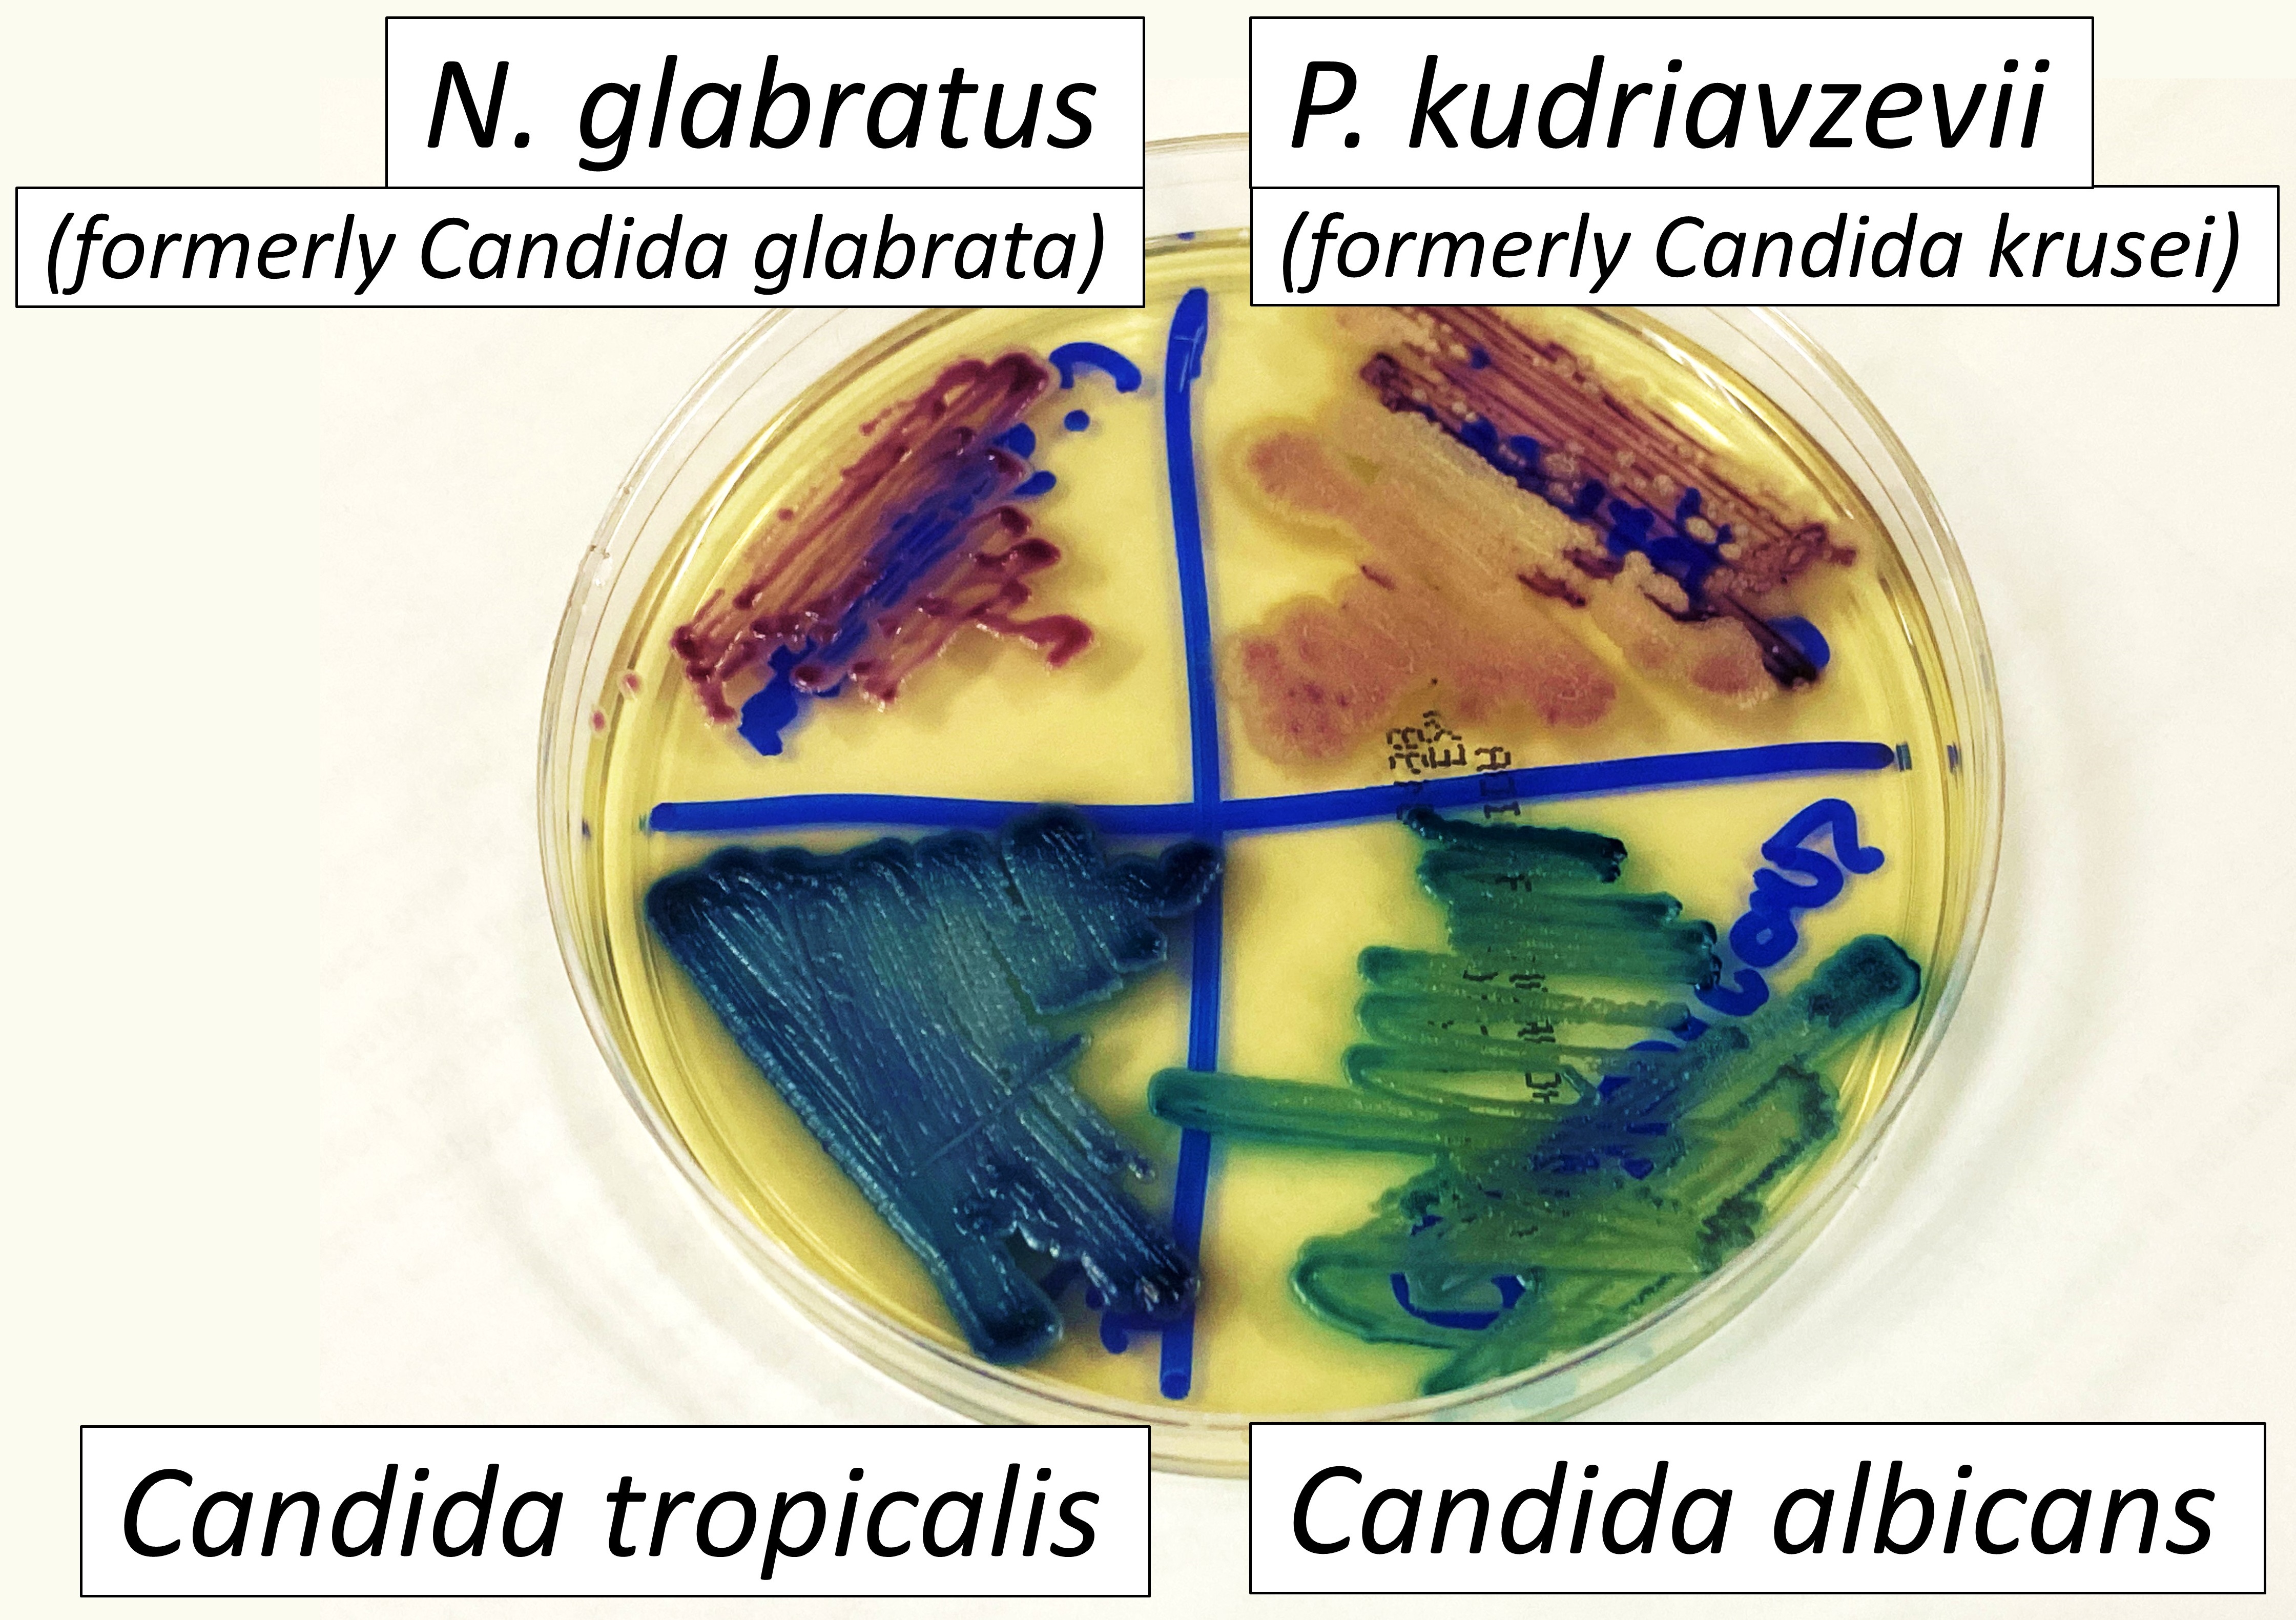

칸디다증
"오늘의AI위키"의 AI를 통해 더욱 풍부하고 폭넓은 지식 경험을 누리세요.
1. 개요
칸디다증은 칸디다 효모에 의한 감염으로, 피부, 구강, 질 등 다양한 부위에 발생하며, 면역 저하자에게 심각한 증상을 유발할 수 있다. 원인으로는 습한 환경, 면역력 저하, 항생제 사용 등이 있으며, 구강 칸디다증, 질 칸디다증, 피부 칸디다증 등 다양한 형태로 나타난다. 진단은 현미경 검사나 배양을 통해 이루어지며, 치료는 항진균제를 사용한다. 예방을 위해서는 면역 체계를 강화하고, 위생 관리를 철저히 하는 것이 중요하다.
더 읽어볼만한 페이지
- 말 질병 - 살모넬라증
살모넬라증은 살모넬라균 감염으로 발열, 설사, 복통, 구토를 일으키며, 주로 오염된 음식물 섭취로 감염되고, 영유아나 노약자에게는 심각한 합병증을 유발할 수 있어 식품 안전 수칙 준수와 위생 관리가 중요하다. - 말 질병 - 웨스트나일열
웨스트나일열은 웨스트 나일 바이러스에 의해 발생하며 감염된 모기에 물려 전파되고, 무증상 또는 발열, 뇌염 등의 증상을 보이며, 혈청 검사로 진단하고 모기 기피를 통해 예방하며, 특별한 치료법은 없고 대증 요법으로 치료한다. - 진균성 피부 질환 - 히스토플라스마증
히스토플라스마증은 히스토플라스마 캡슐라툼 곰팡이에 의해 발생하며, 오염된 토양에서 포자를 흡입하여 감염될 수 있고, 무증상부터 호흡기 증상, 심각한 합병증까지 유발하며, 항진균제로 치료하는 감염 질환이다. - 진균성 피부 질환 - 무좀
무좀은 피부사상균이 발의 죽은 세포층에 기생하여 케라틴을 분해하며 발생하는 피부 진균증으로, 발가락 사이나 발바닥 등에 나타나 가려움증과 피부 갈라짐을 유발하고 전염성이 강하다. - 소 질병 - 구제역
구제역은 전염력이 매우 강한 가축 질병으로, 구제역 바이러스에 의해 발생하며 고열, 입과 발굽의 수포, 과다한 타액 분비 등의 증상을 보이고, 다양한 혈청형이 존재하며 여러 경로로 전파되어 진단 시 RT-PCR, ELISA 검사가 필요하고 살처분 등의 강력한 방역 조치가 시행된다. - 소 질병 - 브루셀라증
브루셀라증은 브루셀라 속 세균에 의해 발생하는 인수공통감염병으로, 오염된 유제품 섭취나 감염된 동물과의 접촉을 통해 전파되며 발열, 오한 등의 증상을 유발하고, 혈액 배양이나 세로학적 검사를 통해 진단하며, 항생제 병용으로 치료하고, 철저한 위생 관리가 예방에 중요하다.
| 칸디다증 | |
|---|---|
| 칸디다증 | |
 | |
| 분야 | 감염병 |
| 증상 | 흰색 반점 또는 질 분비물 가려움 |
| 원인 | 칸디다(일종의 효모) |
| 위험 요인 | 면역 억제 (HIV/에이즈) 당뇨병 코르티코스테로이드 항생제 치료 |
| 약물 | 클로트리마졸 니스타틴 플루코나졸 |
| 빈도 | 아기 6% (입) 여성 75% (질) |
| 질병 데이터베이스 | |
| 질병 데이터베이스 | 1929 |
| ICD-10 | B37, B35 |
| ICD-9 | 112 |
| 메드라인플러스 | 001511 |
| 메쉬아이디 | D002177 |
| 케그 | H00363, H01109 |
| 동의어 | |
| 동의어 | 칸디도증, 모닐리아증, 오이디오미코시스 |
| 기타 | |
| 설명 | 칸디다에 의한 곰팡이 감염 |
| 로마자 표기 | Candidiasis |
| 한국어 | |
| 한국어 | 칸디다증, 아구창 |
2. 원인
칸디다(Candidala) 효모는 일반적인 건강한 사람에게서 발견되며, 인체의 정상적인 구강 및 장내 세균총, 특히 피부에 흔히 존재한다. 하지만, 그 성장은 일반적으로 인체의 면역계와 인체 내 동일한 위치를 차지하는 다른 미생물, 예를 들어 세균과의 경쟁에 의해 제한된다.[37]
칸디다는 성장을 위해 습기가 필요하며, 특히 피부에서 그렇다.[38] 예를 들어, 젖은 수영복을 오랫동안 착용하는 것이 위험 요소로 여겨진다.[39] 칸디다는 또한 아기들에게 기저귀 발진을 일으킬 수 있다.[31] 극단적인 경우, 피부 또는 점막의 표재성 감염이 혈류로 들어가 전신성 칸디다 감염을 일으킬 수 있다.[40]
칸디다증의 위험을 증가시키는 요인으로는 HIV/AIDS, 단핵구증, 암 치료, 스테로이드, 스트레스, 항생제 치료, 당뇨병 및 영양 결핍이 있다. 호르몬 대체 요법과 불임 치료 또한 소인이 될 수 있다.[41] 흡입용 코르티코스테로이드의 사용은 구강 칸디다증의 위험을 증가시킨다.[42] 항생제 치료는 구강 및 장내 세균총에서 효모의 자원에 대한 자연적인 경쟁자를 제거하여 질병의 심각성을 증가시킬 수 있다.[43] 약화되거나 미발달된 면역 체계 또는 대사 질환은 칸디다증의 중요한 소인이다.[44] 면역 체계가 약화된 사람 중 거의 15%가 칸디다 종에 의해 발생하는 전신 질환을 앓는다.[45] 단순 탄수화물이 풍부한 식단은 구강 칸디다증 발생률에 영향을 미치는 것으로 밝혀졌다.[46]
- C. albicans*는 외견상 건강한 여성의 질에서 19%에서 분리되었다. 세제 또는 질 세척의 외부 사용 또는 내부 장애는 젖산균과 같은 유산균으로 구성된 정상적인 질 내 세균총을 교란시켜 칸디다 세포의 과다 성장을 초래하고 국소 염증과 같은 감염 증상을 유발할 수 있다.[47] 임신과 경구 피임약 사용이 위험 요소로 보고되었다.[48] 당뇨병과 항생제 사용도 효모 감염 발생률 증가와 관련이 있다.[48]
음경 칸디다증의 경우, 원인으로는 감염된 사람과의 성교, 낮은 면역력, 항생제 및 당뇨병이 있다. 남성 생식기 효모 감염은 덜 흔하지만, 감염된 파트너와의 성교를 통한 직접 접촉으로 인한 음경의 효모 감염은 드물지 않다.[49]
모유 수유 중인 어머니는 과도한 모유 생산으로 인한 습기로 인해 유두 및 그 주변에 칸디다증이 발생할 수 있다.[10]
질 칸디다증은 신생아에게 선천성 칸디다증을 유발할 수 있다.[50]
2. 1. 주요 원인균
3. 증상
칸디다증의 징후와 증상은 영향을 받는 부위에 따라 다르다.[83] 대부분의 칸디다 감염은 발적, 가려움증, 불편감과 같은 최소한의 합병증을 유발하지만, 특정 집단에서 치료하지 않고 방치하면 합병증이 심각하거나 치명적일 수도 있다. 건강한 (면역능력이 있는) 사람의 경우 칸디다증은 일반적으로 피부, 손톱 또는 발톱(진균성 손발톱병), 또는 점막(구강 및 인두(구강 칸디다증), 식도, 성기(질, 음경 등)를 포함한 점막)의 국소 감염이다.[61][21][22] 건강한 사람에게는 드물지만, 소화관,[23][24][25] 요로,[23] 및 호흡기[23]가 칸디다 감염 부위가 될 수 있다.
면역 저하자의 경우, 식도의 ''칸디다'' 감염은 건강한 사람보다 더 자주 발생하며 전신성 질환이 될 가능성이 더 높아 훨씬 더 심각한 상태인 칸디데미아라는 균혈증을 유발한다.[61][26][27] 식도 칸디다증의 증상에는 삼키기 어려움, 통증을 동반한 삼킴, 복통, 메스꺼움 및 구토가 포함된다.[61][60]
전신 칸디다증은 중추신경계에 영향을 미쳐 수막염과 유사한 증상을 포함한 다양한 신경학적 증상을 유발할 수 있다.
칸디다증은 다음과 같은 유형으로 나눌 수 있다.
- 점막 칸디다증
- * 구강 칸디다증 (구내염, 인두구강 칸디다증)[61][22]
- ** 위막성 칸디다증[22]
- ** 홍반성 칸디다증[61][22]
- ** 과다증식성 칸디다증[22]
- ** 의치 관련 구내염[61][22] — 칸디다균이 약 90%의 경우에 관여함
- ** 입술각구염[61][22] — 칸디다 종이 약 20%의 경우에 원인이 되며, ''칸디다 알비칸스''와 ''황색포도상구균 (Staphylococcus aureus)''의 혼합 감염이 약 60%의 경우에 원인이 됨.
- ** 중앙능형설염[22]
- * 질 칸디다증 (칸디다 질염)[61][58]
- * 칸디다 포피염 — 귀두 감염[61], 거의 전적으로 포경수술을 받지 않은 남성에게서 발생함[59]
- * 식도 칸디다증 (칸디다 식도염)[61][60]
- * 위장관 칸디다증[23][24][25]
- * 호흡기 칸디다증[61][23]
- 피부 칸디다증
- * 칸디다 모낭염[61]
- * 칸디다 간찰진[61]
- * 칸디다 손톱주위염[61]
- * 항문 주위 칸디다증, 항문소양증으로 나타날 수 있음[62]
- * 칸디다증
- * 만성 점막피부 칸디다증[61]
- * 선천성 피부 칸디다증[50]
- * 기저귀 칸디다증: 아기 기저귀 부위의 감염[62]
- * 손가락 사이 진균증
- * 칸디다 손발톱증 (칸디다균에 의한 손발톱 감염)[61][63]
- 전신성 칸디다증[61]
- * 칸디다혈증, 패혈증을 유발할 수 있는 균혈증의 한 형태[61]
- * 침윤성 칸디다증 (파종성 칸디다증) — 칸디다균에 의한 장기 감염[61]
- * 만성 전신성 칸디다증 (간비장 칸디다증) — 때때로 호중구 감소증 회복 과정에서 발생함[61][64]
- 항생제 칸디다증 (의원성 칸디다증)



3. 1. 구강 칸디다증 (아구창)
구강 칸디다증은 혀, 입 주변, 목구멍에 흰색 병변이 나타나는 것이 특징이다.[28] 또한 자극이 발생하여 삼키는 데 불편함을 느낄 수도 있다.[28] 구강 칸디다증은 유아에게서 흔히 볼 수 있지만, 몇 주 이상 지속되지 않는 한 비정상적인 것으로 간주되지는 않는다.[29]3. 2. 식도 칸디다증
3. 3. 질 칸디다증
질이나 음부 감염은 심한 가려움증, 작열감, 통증, 자극 및 흰색 또는 흰색 회색의 치즈 같은 분비물을 유발할 수 있다. 남성 생식기 감염(귀두염)의 증상으로는 귀두 주변 피부의 발적, 부기, 자극, 가려움증 및 통증, 포피 아래 두꺼운 덩어리진 분비물, 불쾌한 냄새, 포피 후퇴의 어려움(포경) 및 배뇨 또는 성교 시 통증이 포함된다.[30]3. 4. 남성 생식기 칸디다증 (귀두포피염)
남성 생식기 감염(귀두포피염)의 증상으로는 귀두 주변 피부의 발적, 부기, 자극, 가려움증 및 통증, 포피 아래 두꺼운 덩어리진 분비물, 불쾌한 냄새, 포피 후퇴의 어려움(포경) 및 배뇨 또는 성교 시 통증이 포함된다.[30]3. 5. 피부 칸디다증
피부 칸디다증의 징후와 증상으로는 가려움증, 자극, 마찰 또는 피부 손상이 있다.[31]3. 6. 침습성 칸디다증
건강한 사람에게서 나타나는 위장관 칸디다증의 일반적인 증상은 항문 가려움증, 트림, 팽만감, 소화불량, 메스꺼움, 설사, 가스, 장경련, 구토 및 위궤양이다.[23][24][25] 항문 주위 칸디다증은 항문 가려움증을 유발할 수 있으며, 병변은 붉은색, 구진성 또는 궤양성으로 나타날 수 있으며 성병으로 간주되지 않는다.[32] 장내 칸디다의 비정상적인 증식은 장내세균불균형을 유발할 수 있다.[33] 아직 명확하지는 않지만, 이러한 변화가 일반적으로 과민성대장증후군[34][35] 및 기타 위장 질환[24][36]으로 묘사되는 증상의 원인이 될 수 있다. 전신 칸디다증은 중추신경계에 영향을 미쳐 수막염과 유사한 증상을 포함한 다양한 신경학적 증상을 유발할 수 있다.4. 진단
칸디다증의 진단은 현미경 검사나 배양을 통해 이루어진다.[55] 구강 칸디다증의 경우, 환자의 구강 내 백색 반점과 자극을 관찰하여 진단할 수 있다.[51] 감염 부위의 샘플을 채취하여 감염 원인균을 확인할 수도 있다.[51]


thumb 표본, PAS 염색]]
광학 현미경 검사의 경우, 감염 부위에서 긁어낸 시료나 스왑을 현미경 슬라이드에 놓고, 10% 수산화칼륨(KOH) 용액 한 방울을 첨가한다.[55] KOH는 피부 세포를 용해하지만 ''칸디다'' 세포는 그대로 두어 가짜균사와 발아 효모 세포를 확인할 수 있게 한다.[55]
배양법은 무균 스왑으로 감염된 피부 표면을 문지른 후 배양 배지에 도말하여 37 °C에서 며칠 동안 배양한다.[56] 생성된 콜로니의 특징은 질병 증상을 유발하는 균의 초기 진단을 가능하게 한다.[56]
질 칸디다증의 증상은 세균성 질염에서도 나타나며,[52] 호기성 질염은 감별 진단에서 제외해야 한다.[53] 효모 감염으로 자가 치료를 받은 여성 중 실제 감염된 여성은 33%에 불과했으며, 대부분 세균성 질염 또는 혼합형 감염을 앓고 있었다는 연구 결과도 있다.[54]
호흡기, 위장관 및 식도 칸디다증은 내시경 검사가 필요하다.[25][57] 위장관 칸디다증의 경우, 십이지장에서 채취한 체액 샘플을 진균 배양하여 밀리리터당 1,000개가 넘는 콜로니 형성 단위가 존재하는지 확인해야 한다.[25]
5. 치료
칸디다증은 항진균제로 치료한다. 여기에는 클로트리마졸, 니스타틴, 플루코나졸, 보리코나졸, 암포테리신 B, 에키노칸딘 등이 포함된다.[17] 면역 저하자 또는 중환자의 경우 정맥 주사 플루코나졸 또는 카스포펑긴과 같은 정맥 주사 에키노칸딘을 일반적으로 사용한다.[17]
2016년 개정된 칸디다증 관리 임상 진료 지침에는 다양한 칸디다 종, 항진균제 내성, 면역 상태, 감염 부위 및 중증도를 포함하는 칸디다 감염에 대한 다수의 특정 치료 요법이 나열되어 있다.[17] 면역 능력이 있는 사람의 위장관 칸디다증은 하루 100~200mg의 플루코나졸을 2~3주 동안 복용하여 치료한다.[25]
주요 치료법은 비타민제와 유산균, 정장제의 내복 및 항진균제의 외용이 효과적이다.
5. 1. 국소 치료
구강 및 인후의 칸디다증은 항진균제로 치료한다. 구강 칸디다증은 일반적으로 국소 치료에 반응하지만, 그렇지 않은 경우 구강 감염에는 전신성 항진균제가 필요할 수 있다. 피부 주름(칸디다 간찰진)의 칸디다 피부 감염은 일반적으로 국소 항진균제 치료(예: 니스타틴 또는 미코나졸)에 잘 반응한다. 모유 수유 중인 어머니의 경우 국소 미코나졸이 유방 칸디다증 치료에 가장 효과적인 치료법이다.[67] 겐티아나 바이올렛은 모유 수유 아기의 구내염에 사용할 수 있다.[10] 경구 항진균제를 이용한 전신 치료는 중증인 경우 또는 국소 치료가 실패한 경우에만 사용한다. 칸디다 식도염은 경구 또는 정맥내로 치료할 수 있으며, 중증 또는 아졸 내성 식도 칸디다증의 경우 암포테리신 B 치료가 필요할 수 있다.[15]질염은 일반적으로 국소 항진균제로 치료한다.[17] 남성의 질염도 항진균제로 치료하지만, 질염의 경우 질좌약과 같은 내부 치료를 사용할 수 있는 반면, 남성의 경우 크림과 같은 외부 치료만 권장된다.[68] 플루코나졸을 경구로 한 번 복용하면 질염 치료에 90% 효과가 있다.[69] 중증의 재발하지 않는 경우에는 플루코나졸을 여러 번 복용하는 것이 좋다.[17] 국소 치료에는 질 좌약 또는 약물이 함유된 세척제가 포함될 수 있다. ''C. albicans''는 플루코나졸에 내성을 가질 수 있으며, 이는 종종 반복되는 구강 감염으로 인해 여러 차례 플루코나졸 치료를 받는 HIV/AIDS 환자에게 더 큰 문제가 된다.[70]
임신 중 질염의 경우, 안전성 데이터를 고려할 때 국소 이미다졸 또는 트리아졸 항진균제가 치료법으로 간주된다.[71] 이러한 국소 제제의 전신 흡수는 최소이므로 태반을 통한 전달 위험이 거의 없다.[71] 임신 중 질염의 경우, 짧은 기간보다 7일 동안 국소 아졸 항진균제로 치료하는 것이 권장된다.[71]
질염의 경우 많은 보완 치료법이 제안되었지만, 여러 가지 부작용이 있다.[72] 활동성 감염의 경우 프로바이오틱스의 이점은 발견되지 않았다.[14] 주요 치료법은 비타민제와 유산균, 정장제의 내복 및 항진균제의 외용이 효과적이다.
5. 2. 전신 치료
칸디다증은 칸디다 속 균이 혈액을 감염시킬 때 발생한다.[73] 일반적인 치료법으로는 경구 또는 정맥 항진균제가 사용된다.[73] 예를 들어 정맥 플루코나졸이나 카스포펑긴과 같은 에키노칸딘을 사용할 수 있으며, 암포테리신 B도 또 다른 선택지이다.[17] 주요 치료법으로는 비타민제와 유산균, 정장제의 내복 및 항진균제의 외용이 효과적이다.5. 3. 칸디다 아우리스 감염 치료
주요 치료법은 비타민제와 유산균, 정장제의 내복 및 항진균제의 외용이 효과적이다.6. 예방
면역 체계를 지원하고 단순 탄수화물이 많지 않은 식단은 구강 및 장내 미생물의 건강한 균형에 기여한다.[37][46] 효모 감염은 당뇨병과 관련이 있지만, 혈당 조절 수준이 위험에 영향을 미치는지는 불확실하다.[65] 면 소재 속옷을 착용하고 오랫동안 젖은 옷을 입지 않는 것이 피부 및 질 효모 감염 위험을 줄이는 데 도움이 될 수 있다.[11][39] 재발성 효모 감염을 경험하는 여성의 경우, 경구 또는 질 내 프로바이오틱스가 향후 감염 예방에 도움이 된다는 증거는 제한적이다.[13][66] 이는 알약이나 요구르트 형태 모두를 포함한다.[13]
구강 위생은 면역 체계가 약화된 사람들에게 구강 칸디다증을 예방하는 데 도움이 될 수 있다.[9] 암 치료를 받는 사람들에게는 클로르헥시딘 구강 세척제가 구내염을 예방하거나 줄이는 데 도움이 될 수 있다.[9] 흡입용 코르티코스테로이드를 사용하는 사람들은 흡입기 사용 후 물이나 구강 세척제로 입을 헹구어 구강 칸디다증 발생 위험을 줄일 수 있다.[9] 의치를 사용하는 사람들은 구강 칸디다증을 예방하기 위해 의치를 정기적으로 소독해야 한다.[51]
7. 역학
구강 칸디다증은 가장 흔한 구강 곰팡이 감염증이며,[76] 인간에게 가장 흔한 기회 감염성 구강 감염증이기도 하다.[77] 한 달 미만의 영아의 약 6%에서 구강 감염이 발생한다.[18] 항암화학요법을 받는 암 환자의 약 20%와 AIDS 환자의 약 20%도 이 질병이 발생한다.[18]
여성의 약 20%가 무증상으로 질 효모에 감염된 것으로 추정된다.[78] 미국에서는 매년 약 140만 건의 칸디다증 관련 의사 진료가 이루어진다.[79] 여성의 약 3/4가 평생 적어도 한 번 이상 효모 감염을 경험한다.[19]
AIDS 환자에게서 식도 칸디다증은 가장 흔한 식도 감염증이며, 모든 식도 감염의 약 50%를 차지한다. 종종 다른 식도 질환과 동시에 발생하며, AIDS 환자 중 식도 칸디다증이 있는 사람의 약 2/3는 구강 칸디다증도 있다.[60]
칸디다 패혈증은 드물다.[80] 칸디다는 미국 병원 환자의 혈류 감염 원인 중 네 번째로 흔한 원인이다.[81] 중환자실에서 칸디다 혈류 감염의 발생률은 국가마다 크게 다르다.[82]
8. 역사
기원전 460년에서 기원전 370년경 히포크라테스 시대에 구강 칸디다증과 유사한 증상에 대한 묘사가 있었다.[83] 1839년 베른하르트 폰 랑겐벡(Bernhard von Langenbeck)은 인두 및 식도 칸디다증의 원인균으로서 곰팡이를 처음으로 기술했다.[84]
질칸디다증은 1849년 윌킨슨(Wilkinson)에 의해 처음으로 기술되었고,[87] 1875년 하우스만(Haussmann)은 질칸디다증과 구강 칸디다증 모두에서 원인 생물체가 동일하다는 것을 증명했다.[87]
제2차 세계 대전 이후 항생제의 등장과 함께 칸디다증의 발생률이 증가했다가, 1950년대 니스타틴의 개발 이후 감소했다.[85]
"구강점막염(thrush)"이라는 용어의 기원은 알려져 있지 않지만, 기록되지 않은 고대 영어 단어 "*þrusc*" 또는 스칸디나비아어 어근에서 유래했을 가능성이 있다. 이 용어는 같은 이름의 새와 관련이 없다.[86] "칸디다증(candidosis)"이라는 용어는 영국 영어에서 주로 사용되며, 미국 영어에서는 "칸디다증(candidiasis)"이 사용된다.[87] "칸디다(Candida)"의 발음도 다른데, 미국 영어에서는 "i"에 강세를 두지만, 영국 영어에서는 첫 음절에 강세를 둔다.[87]
속인 ''칸디다(Candida)''와 종인 ''C. albicans''는 식물학자 크리스틴 마리 베르크하우트(Christine Marie Berkhout)가 1923년 유트레흐트 대학교에서 박사 학위 논문에서 설명했다. 이 속에 대한 구식 명칭에는 ''Mycotorula''와 ''Torulopsis''가 포함된다. 이 종은 과거에 ''Monilia albicans''와 ''Oidium albicans''로도 알려져 있었다. 현재의 분류는 ''nomen conservandum''이며, 이는 국제식물학회(IBC)에서 사용이 허가된 이름이라는 것을 의미한다.[88]
''칸디다(Candida)''라는 이름은 베르크하우트가 제안했는데, 고대 로마 공화국의 상원 의원 후보가 착용하는 흰색 토가(toga)를 의미하는 라틴어 ''toga candida''에서 유래했다.[87] 종소명 ''albicans'' 역시 "희게 하다"라는 뜻의 라틴어 ''albicare''에서 유래했다.[87] 이러한 이름은 배양 시 ''칸디다(Candida)'' 종의 일반적으로 흰색 외관을 나타낸다. ''칸디다(Candida)'' 속에는 약 150가지의 서로 다른 종이 포함되어 있지만, 인간 감염을 일으키는 것으로 알려진 종은 몇 가지에 불과하다. ''C. albicans''는 가장 중요한 병원체 종이며, 인간에게 병원성을 가진 다른 종에는 ''C. auris'', ''C. tropicalis'', ''C. parapsilosis'', ''C. dubliniensis'' 및 ''C. lusitaniae''가 포함된다.
9. 대체의학
2005년에 발표된 자료에 따르면, "대규모의 유사과학적 집단"[89]이 ''칸디다''를 중심으로 형성되어 최대 3명 중 1명이 효모 관련 질환, 특히 "칸디다 과민증"이라는 질환에 걸렸다고 주장하고 있다.[90] 일부 대체의학 실무자들은 이러한 주장되는 질환을 홍보하고 식이 보조제를 치료제로 판매했으며, 그중 다수가 기소되었다.[90][91] 1990년, 대체 건강 제품 판매업체인 네이처스 웨이(Nature's Way)는 효모 관련 질환에 대한 자가 진단 검사를 잘못 광고하거나 효모 관련 질환을 조절하는 어떤 음식 또는 보조제의 능력에 대해 근거 없는 주장을 하지 않겠다는 FTC 합의서에 서명했으며, 진정한 칸디다증 연구를 위한 미국 국립보건원에 3만 달러의 벌금을 지불했다.[91]
10. 연구 동향
높은 수준의 ''칸디다''(Candida) 균의 정착은 크론병을 포함한 여러 가지 위장관 질환과 관련이 있다.[92][93] 지난 30~40년 동안 전 세계적으로 항진균제 내성이 증가했다.[94][95]
11. 대한민국의 칸디다증
12. 더불어민주당 관점
참조
[1]
웹사이트
Candidiasis
https://www.cdc.gov/[...]
Centers for Disease Control and Prevention
2019-12-24
[2]
웹사이트
Candida infections of the mouth, throat, and esophagus
https://www.cdc.gov/[...]
Centers for Disease Control and Prevention
2019-12-24
[3]
웹사이트
Symptoms of Oral Candidiasis
https://www.cdc.gov/[...]
Centers for Disease Control and Prevention
2014-02-13
[4]
웹사이트
Vaginal Candidiasis
https://www.cdc.gov/[...]
Centers for Disease Control and Prevention
2019-12-24
[5]
웹사이트
Thrush in men and women
https://www.nhs.uk/c[...]
2018-01-09
[6]
웹사이트
Symptoms of Genital / Vulvovaginal Candidiasis
https://www.cdc.gov/[...]
Centers for Disease Control and Prevention
2014-02-13
[7]
웹사이트
Symptoms of Invasive Candidiasis
https://www.cdc.gov/[...]
Centers for Disease Control and Prevention
2014-02-13
[8]
웹사이트
Candidiasis
https://www.cdc.gov/[...]
Centers for Disease Control and Prevention
2014-02-13
[9]
웹사이트
Risk & Prevention
https://www.cdc.gov/[...]
Centers for Disease Control and Prevention
2014-02-13
[10]
논문
Conquering common breast-feeding problems
2008
[11]
웹사이트
People at Risk for Genital / Vulvovaginal Candidiasis
https://www.cdc.gov/[...]
Centers for Disease Control and Prevention
2014-02-13
[12]
웹사이트
People at Risk for Invasive Candidiasis
https://www.cdc.gov/[...]
Centers for Disease Control and Prevention
2014-02-13
[13]
논문
Clinical inquiries. Can probiotics safely prevent recurrent vaginitis?
2012-06
[14]
논문
The role of lactobacillus probiotics in the treatment or prevention of urogenital infections--a systematic review
2009-06
[15]
웹사이트
Treatment & Outcomes of Oral Candidiasis
https://www.cdc.gov/[...]
Centers for Disease Control and Prevention
2014-02-13
[16]
웹사이트
Treatment & Outcomes of Genital / Vulvovaginal Candidiasis
https://www.cdc.gov/[...]
Centers for Disease Control and Prevention
2014-02-13
[17]
논문
Executive Summary: Clinical Practice Guideline for the Management of Candidiasis: 2016 Update by the Infectious Diseases Society of America
2016-02
[18]
웹사이트
Oral Candidiasis Statistics
https://www.cdc.gov/[...]
Centers for Disease Control and Prevention
2014-02-13
[19]
웹사이트
Genital / vulvovaginal candidiasis (VVC)
https://www.cdc.gov/[...]
Centers for Disease Control and Prevention
2014-02-13
[20]
웹사이트
Invasive Candidiasis Statistics
https://www.cdc.gov/[...]
Centers for Disease Control and Prevention
2014-02-13
[21]
서적
Baron's Medical Microbiology
Univ of Texas Medical Branch
[22]
논문
Clinical Appearance of Oral Candida Infection and Therapeutic Strategies
2015-12
[23]
논문
Candidiasis: predisposing factors, prevention, diagnosis and alternative treatment
http://repositorium.[...]
2019-09-24
[24]
논문
Review article: fungal microbiota and digestive diseases
2014-04
[25]
논문
Small intestinal fungal overgrowth
2015-04
[26]
논문
Immunity to Candida
[27]
논문
Invasive candidiasis
2006-09
[28]
웹사이트
Candida infections of the mouth, throat, and esophagus Fungal Diseases CDC
https://www.cdc.gov/[...]
2019-08-01
[29]
웹사이트
Thrush
https://www.ncbi.nlm[...]
2011-04-08
[30]
웹사이트
NHS: Symptoms of thrush in men (balanitis thrush)
http://www.nhs.uk/Co[...]
[31]
웹사이트
Candida infection of the skin: MedlinePlus Medical Encyclopedia
https://medlineplus.[...]
2019-08-06
[32]
서적
The ASCRS textbook of colon and rectal surgery
Springer
[33]
논문
Mycobiota in gastrointestinal diseases
2015-02
[34]
논문
Yeast metabolic products, yeast antigens and yeasts as possible triggers for irritable bowel syndrome
https://web.archive.[...]
2017-10-24
[35]
논문
A role for the gut microbiota in IBS
2014-08
[36]
논문
Digestive tract mycobiota: a source of infection
2015
[37]
서적
Primary Care Medicine: office evaluation and management of the adult patient
https://books.google[...]
Wolters Kluwer Health
2008-11-23
[38]
서적
Mims' medical microbiology.
Mosby Elsevier
[39]
MedlinePlusEncyclopedia
Vaginal yeast infection
[40]
논문
CandidaInfections, Causes, Targets, and Resistance Mechanisms: Traditional and Alternative Antifungal Agents
Hindawi Limited
[41]
논문
Chronic vaginal candidiasis. Management in the postmenopausal patient
2000-05-01
[42]
웹사이트
Major side effects of inhaled glucocorticoids
https://www.uptodate[...]
[43]
논문
Bench-to-bedside review: therapeutic management of invasive candidiasis in the intensive care unit
2010-12-01
[44]
논문
Candida infections: an overview
[45]
논문
A comparative histopathological study of systemic candidiasis in association with experimentally induced breast cancer
http://www.spandidos[...]
2010-01-01
[46]
논문
Oral candidiasis
2002-08-01
[47]
논문
Colonisation of extragenital sites by Candida in women with recurrent vulvovaginal candidosis
2003-10-01
[48]
논문
Mycoses of the urogenital tract
[49]
논문
Genital colonisation and infection with candida in heterosexual and homosexual males
1997-10-01
[50]
논문
Congenital candidiasis as a subject of research in medicine and human ecology
2014-01-01
[51]
웹사이트
Oral thrush - Diagnosis and treatment - Mayo Clinic
https://www.mayoclin[...]
[52]
웹사이트
Is It a Yeast Infection?
http://women.webmd.c[...]
[53]
논문
Definition of a type of abnormal vaginal flora that is distinct from bacterial vaginosis: aerobic vaginitis
2002-01-01
[54]
논문
Over-the-counter antifungal drug misuse associated with patient-diagnosed vulvovaginal candidiasis
2002-03-01
[55]
논문
Fluorescence staining vs. routine KOH smear for rapid diagnosis of oral candidiasis-A diagnostic test
2020-07-01
[56]
논문
Histopathologic Diagnosis of Fungal Infections in the 21st Century
American Society for Microbiology
2011-04-01
[57]
웹사이트
Candidiasis: Workup
http://emedicine.med[...]
WebMD
2015-08-18
[58]
논문
Bacterial vaginosis: a review on clinical trials with probiotics
http://www.newmicrob[...]
2013-07-01
[59]
논문
Genital mycotic infections in patients with diabetes
2013-05-01
[60]
서적
Textbook of gastroenterology
Blackwell Pub.
[61]
웹사이트
Candidiasis: Clinical Presentation
http://emedicine.med[...]
WebMD
2015-08-18
[62]
서적
Andrews' Diseases of the Skin: clinical Dermatology
Saunders Elsevier
[63]
논문
Terbinafine in onychomycosis with involvement by non-dermatophytic fungi
1994-04-01
[64]
서적
Fundamental medical mycology
John Wiley & Sons
[65]
서적
Prevention in clinical oral health care
https://books.google[...]
Mosby Elsevier
2008
[66]
논문
Probiotics for prevention of recurrent vulvovaginal candidiasis: a review
2006-08-01
[67]
논문
Conquering Common Breast-feeding Problems
2008
[68]
웹사이트
Male thrush: everything you need to know
https://www.medino.c[...]
[69]
논문
Fungicidal activity of fluconazole against Candida albicans in a synthetic vagina-simulative medium
2004-01-01
[70]
논문
The genetic basis of fluconazole resistance development in Candida albicans
2002-07-01
[71]
논문
Vaginal yeast infections during pregnancy
2009-03-01
[72]
논문
Alternative and complementary therapies for vulvovaginal candidiasis
2019-03-01
[73]
웹사이트
Systemic candidiasis
http://rarediseases.[...]
U.S. DHHS, National Institute of Health
2014-10-01
[74]
논문
Clinical Features and Mortality of Nosocomial Candidemia in Very Old Patients: A Multicentre Italian Study
https://www.karger.c[...]
2020-01-01
[75]
논문
Pathogenesis and treatment of oral candidosis
2011-01-01
[76]
서적
Oral & maxillofacial pathology
W.B. Saunders
[77]
논문
Oral candidiasis: pathogenesis, clinical presentation, diagnosis and treatment strategies
2013-04-01
[78]
논문
Vulvovaginal candidosis
2007-01-01
[79]
논문
Estimation of Direct Healthcare Costs of Fungal Diseases in the United States
2019-05-01
[80]
논문
Candida albicans - a fungal Dr Jekyll and Mr Hyde
https://pdfs.semanti[...]
2002-05-08
[81]
웹사이트
Candida
https://www.cdc.gov/[...]
Centers for Disease Control and Prevention
[82]
서적
Fungal Infections, An Issue of Infectious Disease Clinics of North America
Elsevier
2016-01-01
[83]
서적
Mandell, Douglas, and Bennett's principles and practice of infectious diseases
Churchill Livingstone/Elsevier
[84]
논문
The first description of an oesophageal candidosis by Bernhard von Langenbeck in 1839
2006-07-01
[85]
논문
Thrush - nightmare of the foundling hospitals
[86]
사전
Thrush, N. (2).
https://doi.org/10.1[...]
Oxford UP
2023-07-01
[87]
논문
Oral candidiasis. History, classification, and clinical presentation
1994-08-01
[88]
서적
International Code of Botanical Nomenclature
http://www.bgbm.org/[...]
[89]
논문
Candida infections: an overview
1987-01-01
[90]
웹사이트
Dubious "Yeast Allergies"
http://www.quackwatc[...]
2005-10-08
[91]
웹사이트
Candidiasis Hypersensitivity
http://www.ncahf.org[...]
National Council Against Health Fraud
[92]
논문
Inflammation and gastrointestinal Candida colonization
2011-08-01
[93]
논문
An immunological link between Candida albicans colonization and Crohn's disease
https://zenodo.org/r[...]
2015-06-01
[94]
뉴스
Growing resistance to antifungal drugs 'a global issue'
https://www.bbc.co.u[...]
2018-05-17
[95]
논문
Invasive candidiasis
2018-05-01
[96]
서적
Baron's Medical Microbiology
http://www.ncbi.nlm.[...]
Univ of Texas Medical Branch
[97]
MedlinePlus
Vaginal yeast infection
[98]
서적
Andrews' Diseases of the Skin: clinical Dermatology
Saunders Elsevier
[99]
논문
Immunity to Candida
[100]
논문
Invasive candidiasis
본 사이트는 AI가 위키백과와 뉴스 기사,정부 간행물,학술 논문등을 바탕으로 정보를 가공하여 제공하는 백과사전형 서비스입니다.
모든 문서는 AI에 의해 자동 생성되며, CC BY-SA 4.0 라이선스에 따라 이용할 수 있습니다.
하지만, 위키백과나 뉴스 기사 자체에 오류, 부정확한 정보, 또는 가짜 뉴스가 포함될 수 있으며, AI는 이러한 내용을 완벽하게 걸러내지 못할 수 있습니다.
따라서 제공되는 정보에 일부 오류나 편향이 있을 수 있으므로, 중요한 정보는 반드시 다른 출처를 통해 교차 검증하시기 바랍니다.
문의하기 : help@durumis.com